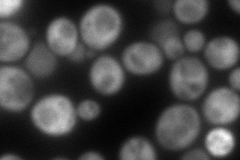
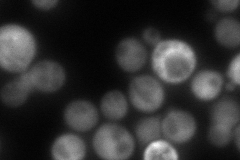

View description
Synthase subunit of trehalose-6-phosphate synthase/phosphatase complex, which synthesizes the storage carbohydrate trehalose; also found in a monomeric form; expression is induced by the stress response and repressed by the Ras-cAMP pathway
Localization:
Intensity:
Fold change:
Significance:
-
C’ GFP library in SD

below threshold15.44 -
N' NOP1pr-GFP in SD

cytosol165.764 -
N' TEF2pr-mCherry in SD
cytosol234.889 -
N' NATIVEpr-GFP in SD
cytosol181.295 -
N' TEF2pr-VC and Cyto-VN in SD

cytosol70.8165 -
C’ GFP library in SD+DTT

cytosol18.881.22No -
C’ GFP library in SD+H2O2

cytosol16.31.05No -
C’ GFP library in Starvation Media

cytosol15.851.02No -
C’ GFP library on the background of Pup2-DaMP

below threshold -
C’ GFP library on the background of CCT mutant

below threshold16.39751.0614No
